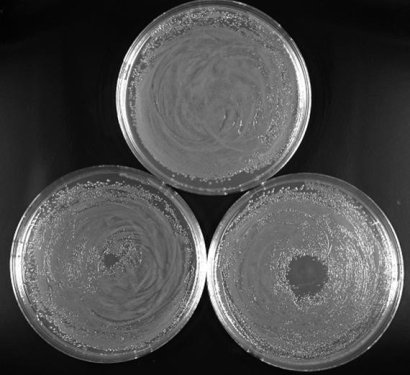

Topics
There are three main research themes at PEMI: 1. Development of low temperature plasma sources; 2. Diagnostics and characterization of plasma; and 3. the biomedical applications of cold plasmas. Each general theme is comprised of several research topics. The following is a detailed list of these research topics:
- Generation of large volume atmospheric pressure cold plasmas
- Generation of cold plasma jets and microjets (and assemblies of these)
- Electrical and optical diagnostics of plasmas
- Effects of cold plasmas on prokaryotic cells
- Effects of cold plasmas on healthy Eukaryotic cells (mammalian cells)
- Effects of cold plasmas on cancer cells
- Selectivity studies
- Plasma-liquid/fluid interactions
Research projects are conducted in two laboratories: 1. The Applied Plasma Technology Laboratory (APTL) where plasma source development and characterization are conducted; 2. The Plasma Biomedical Applications Laboratory (PBAL) where the interaction of plasma with biological cells is studied.
Plasma Medicine Timeline
The biomedical applications of low-temperature atmospheric pressure plasmas (LTP) started in the mid-1990s under a program funded by the Physics and Electronics Directorate of the US Air Force Office of Scientific Research (AFOSR). AFOSR was interested in using LTP to treat soldiers' wounds and sterilizing biotic and abiotic surfaces. Parallel to this work, efforts conducted in Russia showed that plasma-generated nitric oxide (NO) plays a crucial role in enhancing phagocytosis and accelerating the proliferation of fibroblasts. Both in vitro and in vivo experiments were conducted. Finally, and around 2002 a Dutch research group reported that low-temperature plasma can be used to detach mammalian cells without causing necrosis and under some conditions can even lead to apoptosis.
These early groundbreaking research efforts, conducted independently in the US, Russia, and the Netherlands, are the seeds out of which the multidisciplinary field of the biomedical applications of plasma emerged and are the very first foundation upon which the scientific discipline of Plasma Medicine was built.
Milestones
Preliminary research is showing promising possibilities to use low-temperature plasmas in medical applications such as wound healing, the killing of cancer cells, tissue engineering, and the sterilization of reusable heat-sensitive medical instruments. These fascinating developments are posing many technological challenges and are bringing to the forefront fundamental questions regarding the mechanisms of interaction between living organisms and plasma. At the same time, as low-temperature non-equilibrium plasmas come to play an increasing role in biomedical applications, reliable and user-friendly sources need to be developed and characterized. These plasma sources have to meet stringent requirements such as low temperature (at or near room temperature), no risk of arcing, operation at atmospheric pressure, preferably hand-held operation, low concentration of ozone generation, etc.
At Applied Plasma Technology (APTL) we are carrying out research on plasma source development and their characterization and diagnostics. These sources are then used in our biomedical investigations including in dental applications, and evaluation of the suitability of plasma for wound treatment and cancer treatment. One of our main devices is the "plasma pencil" (see picture). This device is capable of emitting a stable, cold plasma plume several centimeters in length.
The electron energy distribution in non-equilibrium discharges plays the most important role in defining the chemistry in the plasma. It is through electron impact excitation and ionization that the charged particles, excited species, and radicals are produced. Increasing the electrons number density and their energy translates to an increase in the production of reactive species and UV radiation emission.
To achieve this increase of ionization and to extend the electron energy distribution to higher values, short high voltage pulses have been used. Using short duration pulses has the advantages of keeping a low average power and not substantially increasing the gas temperature. At APTL we have been using nanoseconds high voltage pulses for many years to produce large volume atmospheric pressure plasmas and plasma jets. One of our jets, the Plasma Pencil, has been shown to launch very high velocity plasma balls or bullets in room air. These plasma bullets can travel several centimeters to deliver reactive species to the surface of a sample.
Many medical tools and instruments are made of heat sensitive materials rendering them unsuitable to be sterilized by heat based methods such as autoclaves. Cold plasma can be a perfect medium to use to decontaminate/sterilize contaminated surfaces of instruments used in the medical or dental theater. In addition, to date, bacteria showed no acquired resistance to plasma treatment. This makes plasma a potential technology to use to fight bacteria that acquire resistance to antibiotics such as MRSA.
Low temperature plasmas produce chemical species including reactive oxygen species (ROS) such as O, O2-, and OH and reactive nitrogen species (RNS) such as NO and NO2 which exhibit strong oxidative properties and/or trigger signaling pathways in biological cells. For example oxidation of the lipids and proteins that constitute the membrane of biological cells leads to the loss of their functions. In such environment bacterial cells were found to die in minutes or even seconds, depending on the strain. However, under some conditions, low temperature plasmas appear to cause little damage to living animal and plant tissues. Having different structures and morphologies, bacterial and mammalian cells exhibit different responses to physical and chemical stresses. For example, skin fibroblast cells are found to remain viable under plasma conditions that can be lethal to bacterial cells. At the Biomedical Applications Laboratory we study the biochemical and physical effects of plasma on healthy cells such as epithelial cells and fibroblasts. The results of this work have direct implications for the use of low temperature plasma for wound healing applications.
Under some conditions, low temperature plasmas can induce apoptosis/ programmed cell death. The induction of apoptosis opened the possibility to use plasma technology to kill cancerous cells. Promising results have so far been achieved in vitro which show that plasma can effectively kill prostate cancer cells, leukemia cells, squamous cells carcinoma, and others.
At the Biomedical Applications Laboratory studies are conducted to elucidate the biochemical effects that LTP induces in cancer cells. This includes investigating cell signaling, apoptotic pathways, and the killing effectiveness of plasma activated media (PAM).